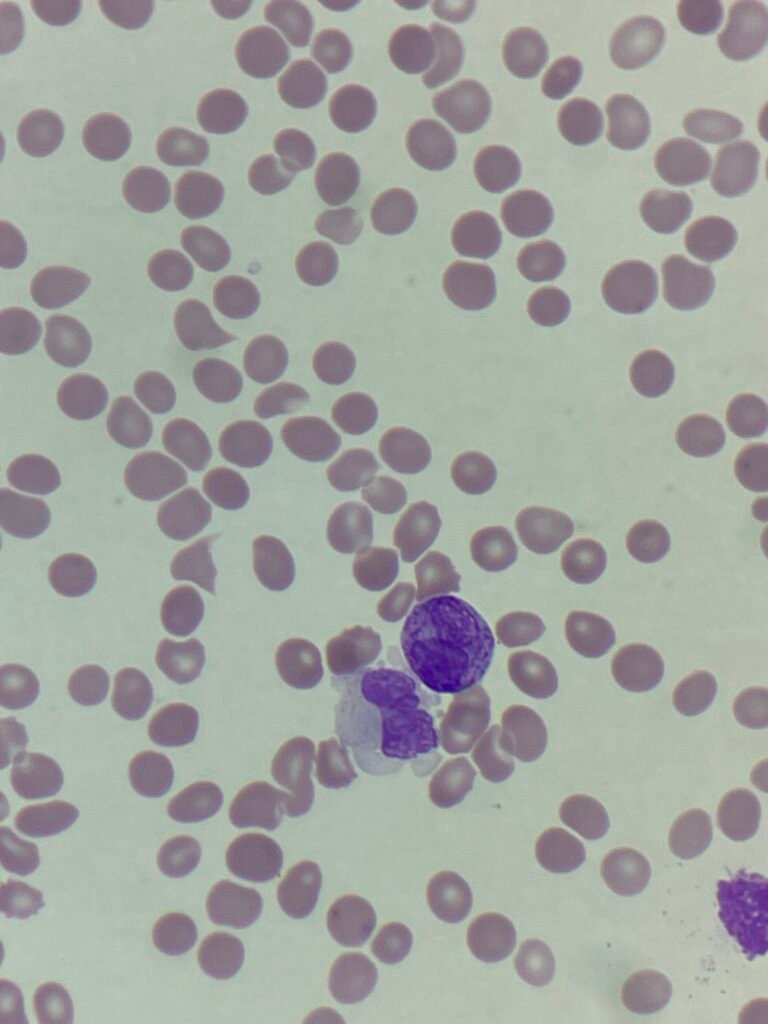
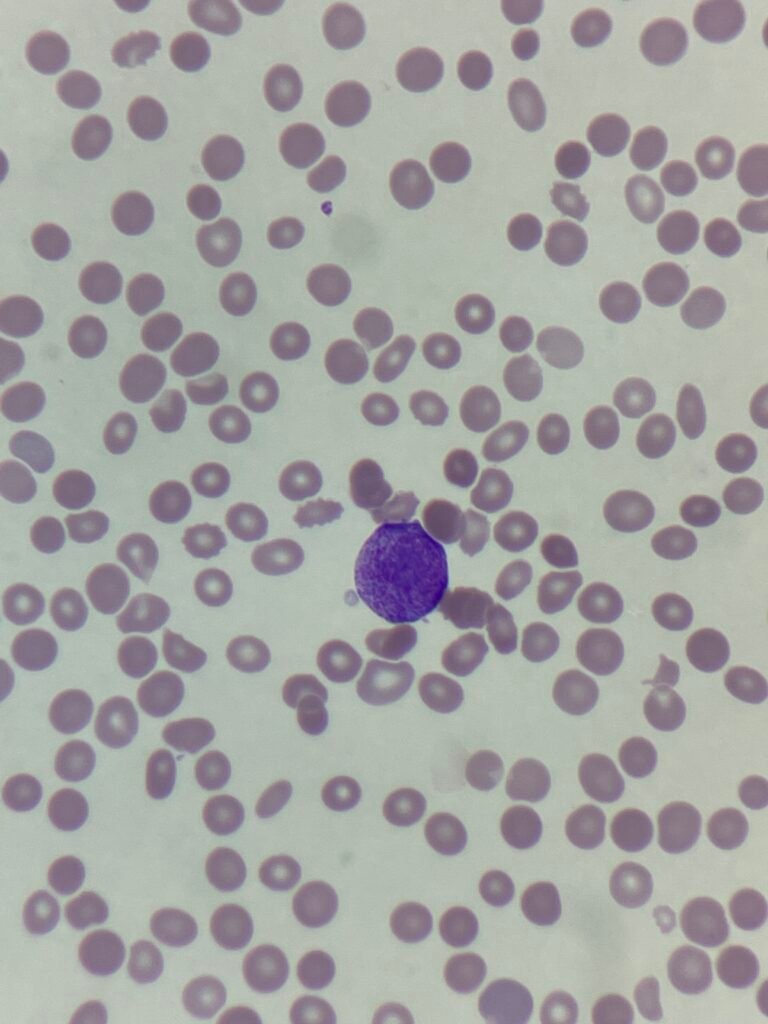
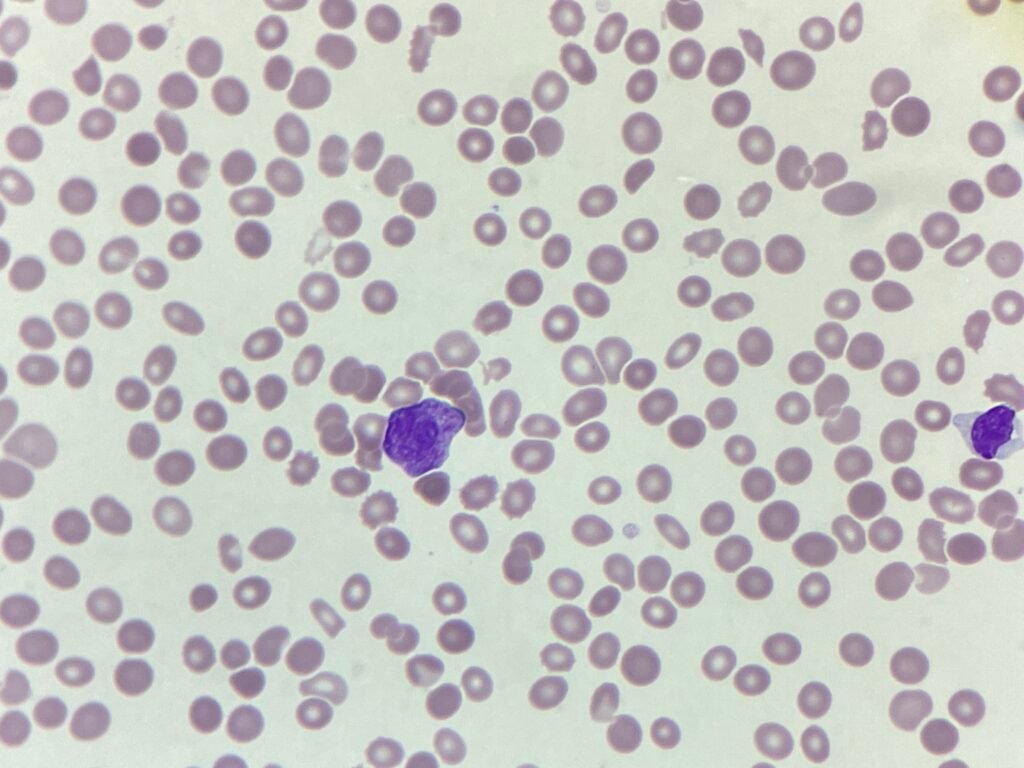
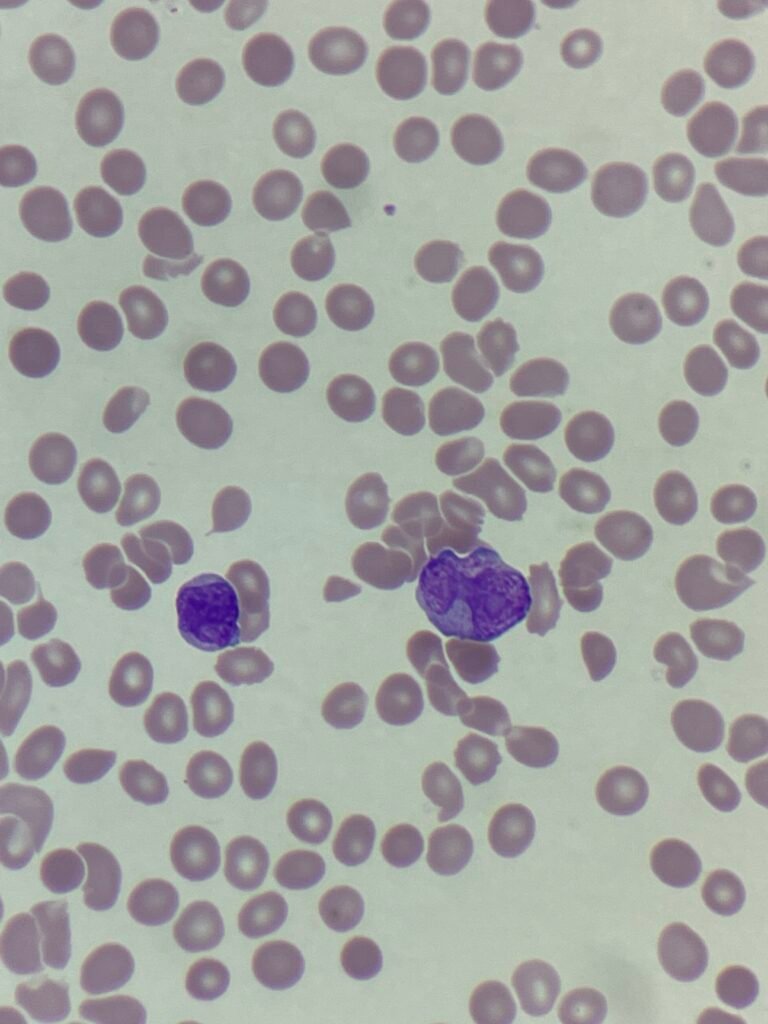
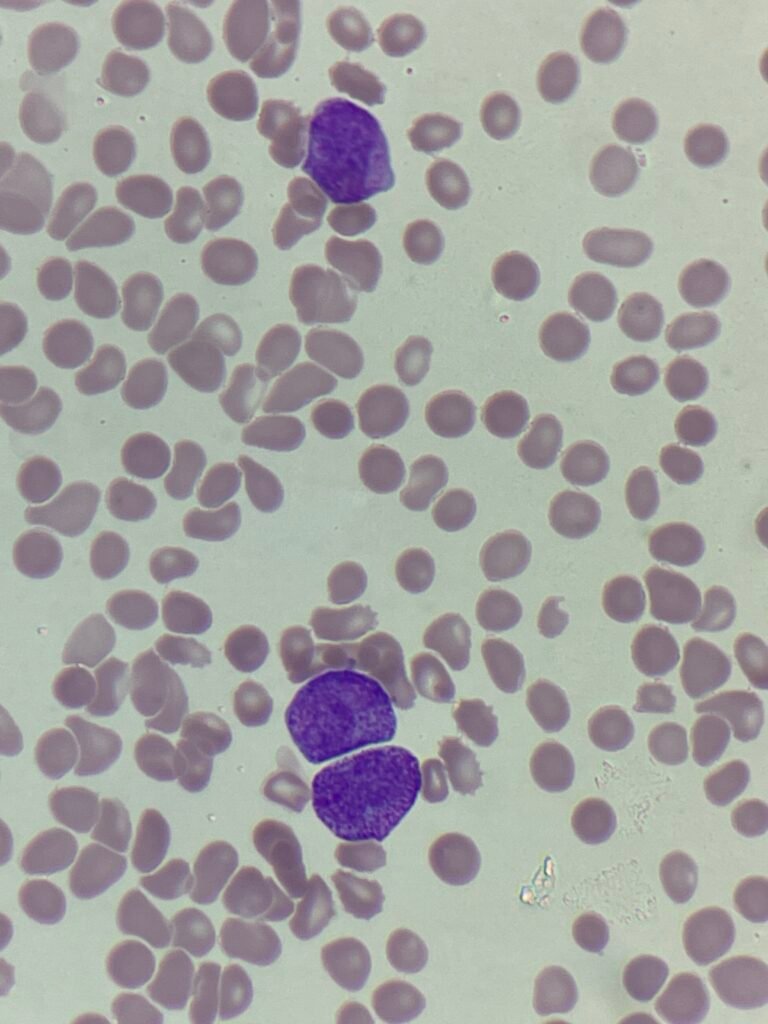
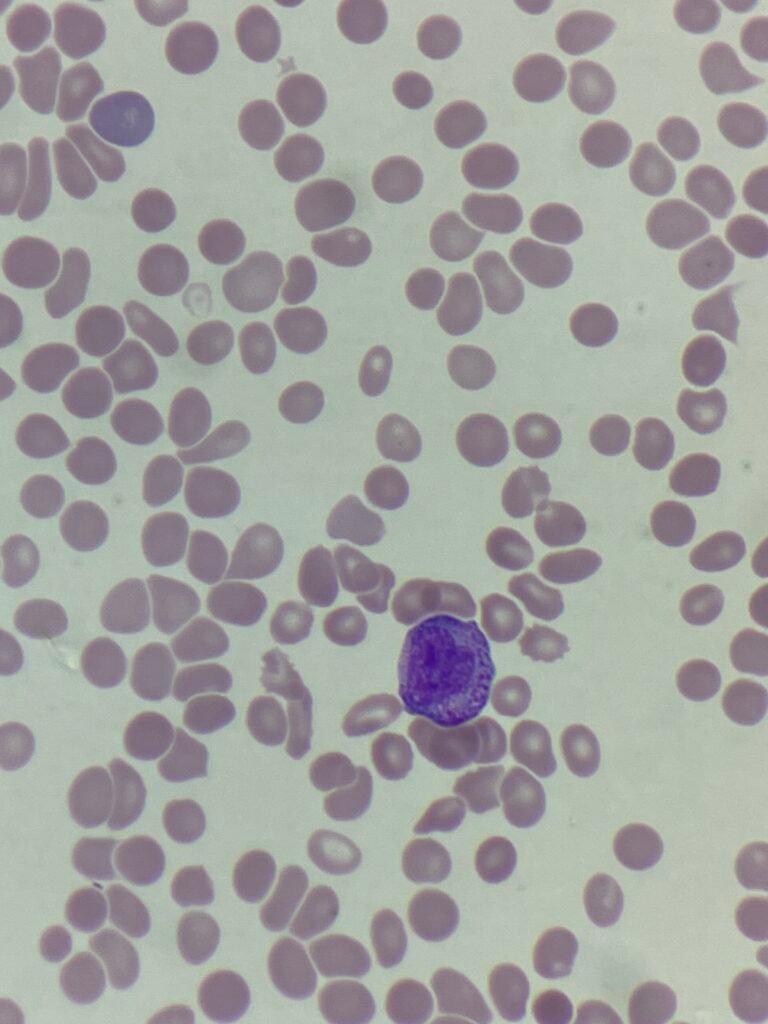

MM251013: Acute promyelocytic leukaemia (APML)
This week’s case was from a 57 year old with some abnormal results:
- Hb: 80 g/L
- Platelets: 26×10⁹/L
- WBC: 35.42 ×10⁹/L
The blood film images showed:

The blood film shows a genuine thrombocytopaenia, with a leukocytosis comprising predominantly of promyelocytes with Auer rods. The cells have immature nucleoli, abundant cytoplasmic granulation and approximately 25%% of the cells are bilobed. These are consistent with acute promyelocytic leukaemia.
APML is considered a medical emergency. The cells release procoagulant and fibrinolytic substances, which cause a severe disseminated intravascular coagulation (DIC)-like state. This means patients can rapidly develop life-threatening bleeding, even before the full diagnosis is confirmed. Delaying therapy (e.g. waiting for flow or molecular confirmation) can be fatal.
The patient was started on ATRA (All-trans retinoic acid). ATRA induces differentiation of the abnormal promyelocytes into mature neutrophils by binding to the PML–RARA fusion protein, which is the defining molecular hallmark of APL.
Here’s how to distinguish the morphological variants on a blood film or bone marrow smear
| Feature | Hypergranular (Classic) | Hypogranular (Microgranular) |
| Cytoplasm | Densely packed with coarse granules | Few or no visible granules |
| Nucleus | Bilobed or folded, sometimes obscured | Multilobed, irregular, open chromatin |
| Auer rods | Numerous; often bundles | Few or single |
| White blood cell count | Normal / low | Often elevated |
If you see:
- Densely granular promyelocytes with bundles of Auer rods → think classic APL.
- Blast-like cells with bilobed or irregular nuclei and little granularity → think microgranular APL (M3v).
- Confirm with flow cytometry (CD33+, CD13+, CD117+, MPO+, HLA-DR–, CD34–) and PML-RARA molecular testing.
Privacy Policy | Refund & Return Policy | Only Cells LTD © 2025
